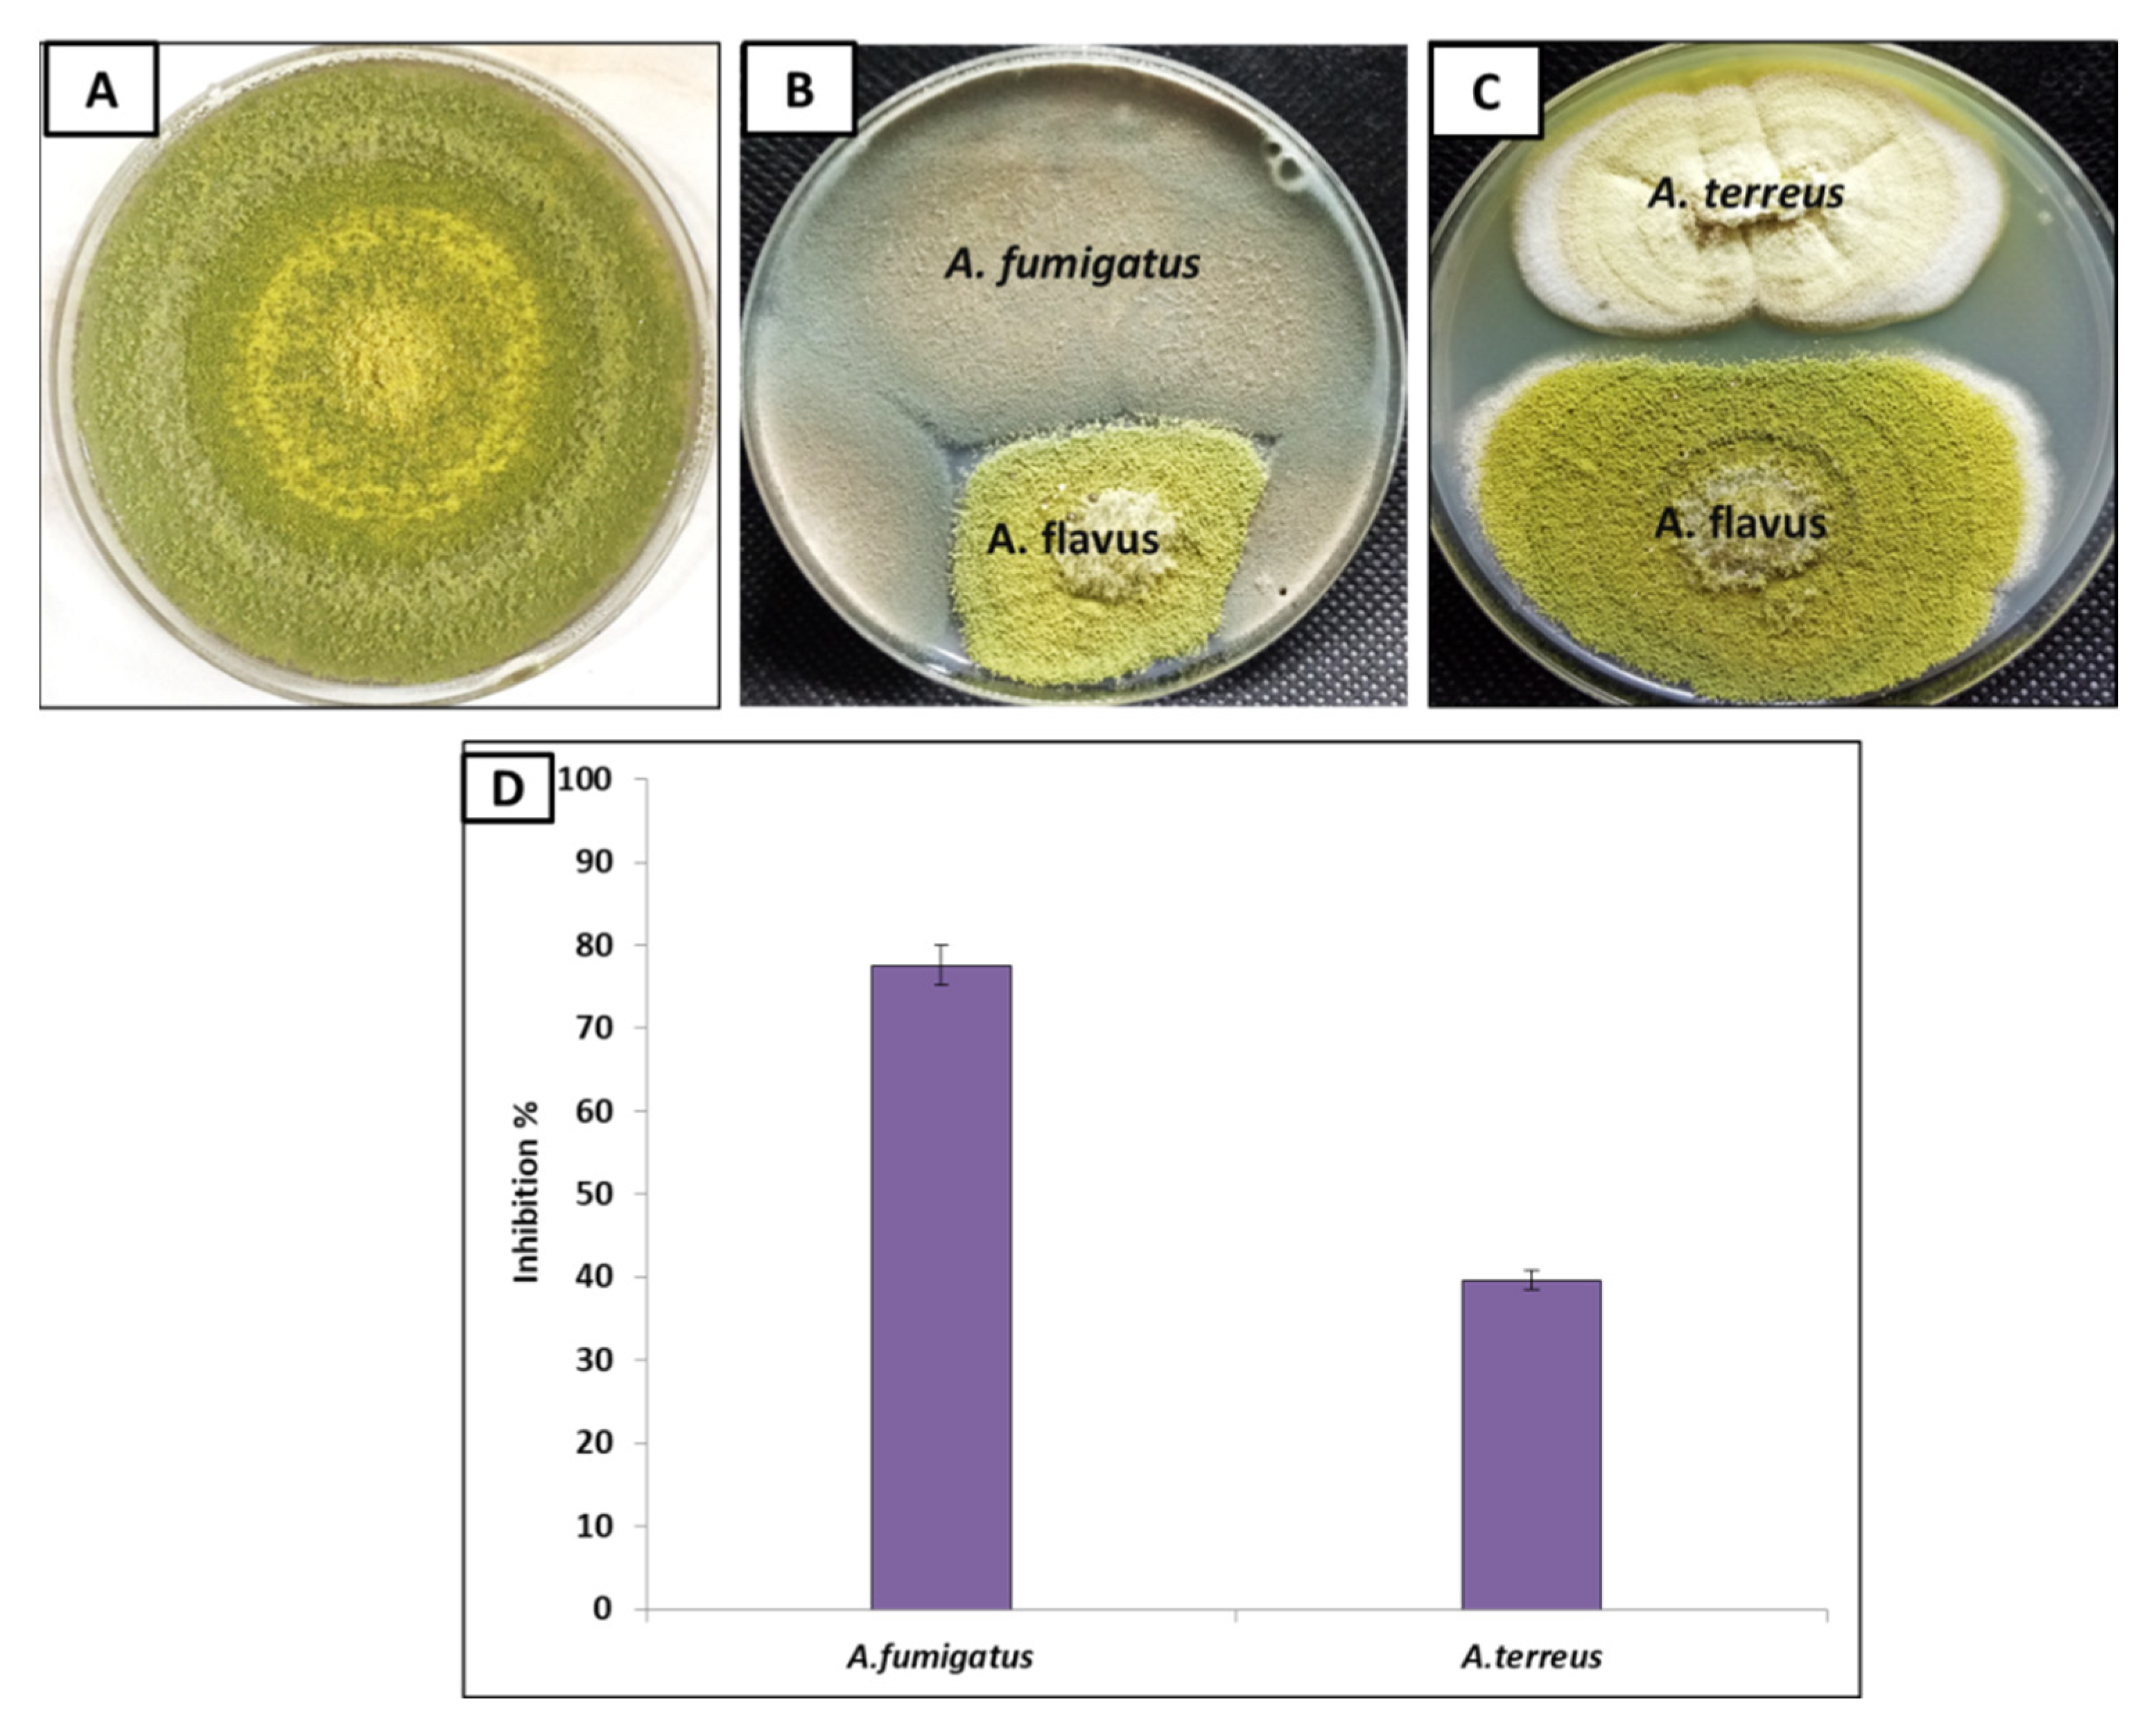

Inhibition of Aspergillus flavus Growth and Aflatoxin Production in Zea mays L. Using Endophytic Aspergillus fumigatus
Abstract
1. Introduction
2. Materials and Methods
2.1. Chemical Reagents
2.2. Isolation of FUNGAL Pathogen
2.3. Isolation of Endophytic Fungi
2.4. Morphological and Molecular Identification of Fungal Pathogen and Endophytes
2.5. In-Vitro Antifungal Activity
2.6. Extraction and Detection of Aflatoxins by High-Performance Liquid Chromatography (HPLC)
2.7. In-Vivo Pot Experiments
2.8. Photosynthetic Pigments
2.9. Lipid Peroxidation (MDA) and Hydrogen Peroxide (H2O2) Contents
2.10. Assessment of Proline Level and Phenolics
2.11. Assessment of Antioxidant Enzymes
2.11.1. Superoxide Dismutase (SOD) Activities
2.11.2. Peroxidase (POD) Activities
2.11.3. Polyphenol Oxidase (PPO) Activities
2.12. Proportion of Mycotoxins
2.13. Microscopic Examination
2.14. Statistical Analysis
3. Results and Discussion
3.1. Isolation and Identification of Fungal Pathogens
3.2. Isolation and Identification of Endophytic Fungi
3.3. Antagonistic Effect of Endophytic A. fumigatus and A. terreus against A. flavus
3.4. In-Vitro Inhibition of Aflatoxins Production of A. flavus Using A. fumigatus in Liquid Medium
3.5. In-Vivo Inhibition of Aflatoxins Production in Infected Corn Plants
3.6. A. fumigatus Attenuates Inhibitions of Maize Seedling Germination and Growth Caused by A. flavus
3.7. Effect of A. fumigatus on Photosynthetic Pigments of Zea maize Seedlings
3.8. Effect of A. fumigatus on Stress Biomarkers
3.9. Improvement in Redox Status by Treatment with A. fumigatus
3.10. Ultra-Structural Study
4. Conclusions
Author Contributions
Funding
Institutional Review Board Statement
Informed Consent Statement
Data Availability Statement
Acknowledgments
Conflicts of Interest
References
- Paterson, R. fungi,(iii) analysing mycotoxin metabolic pathways and (iv) gene microarray analysis were reviewed or men-tioned. To conclude, the issues were addressed in Pater-son & Lima (2010) with different stresses to Magan et al.(2011). Plant Pathol. 2011, 60, 596. [Google Scholar]
- Thompson, M.; Raizada, M. Fungal Pathogens of Maize Gaining Free Passage along the Silk Road. Pathogens 2018, 7, 81. [Google Scholar] [CrossRef] [PubMed]
- Bhusal, K.; Khanal, D. Role of Maize Weevil, Sitophilus zeamais Motsch. on Spread of Aspergillus section flavi in Different Nepalese Maize Varieties. Adv. Agric. 2019, 2019, 7584056. [Google Scholar] [CrossRef]
- Abdelaziz, A.M.; Dacrory, S.; Hashem, A.H.; Attia, M.S.; Hasanin, M.; Fouda, H.M.; Kamel, S.; ElSaied, H. Protective role of zinc oxide nanoparticles based hydrogel against wilt disease of pepper plant. Biocatal. Agric. Biotechnol. 2021, 35, 102083. [Google Scholar] [CrossRef]
- Khalil, A.M.A.; Hashem, A.H.; Abdelaziz, A.M. Occurrence of toxigenic Penicillium polonicum in retail green table olives from the Saudi Arabia market. Biocatal. Agric. Biotechnol. 2019, 21, 101314. [Google Scholar] [CrossRef]
- Motarjemi, Y.; Lelieveld, H. Food Safety Management: A Practical Guide for the Food Industry; Academic Press: Cambridge, MA, USA, 2013. [Google Scholar]
- Zain, M.E. Impact of mycotoxins on humans and animals. J. Saudi Chem. Soc. 2011, 15, 129–144. [Google Scholar] [CrossRef]
- Tola, M.; Kebede, B. Occurrence, importance and control of mycotoxins: A review. Cogent Food Agric. 2016, 2, 1191103. [Google Scholar] [CrossRef]
- Bhat, R.; Rai, R.V.; Karim, A.A. Mycotoxins in Food and Feed: Present Status and Future Concerns. Compr. Rev. Food Sci. Food Saf. 2010, 9, 57–81. [Google Scholar] [CrossRef]
- Murphy, P.A.; Hendrich, S.; Landgren, C.; Bryant, C.M. Food mycotoxins: An update. J. Food Sci. 2006, 71, R51–R65. [Google Scholar] [CrossRef]
- Monbaliu, S.; Van Poucke, C.; Detavernier, C.; Dumoulin, F.; Van De Velde, M.; Schoeters, E.; Van Dyck, S.; Averkieva, O.; Van Peteghem, C.; De Saeger, S. Occurrence of Mycotoxins in Feed as Analyzed by a Multi-Mycotoxin LC-MS/MS Method. J. Agric. Food Chem. 2009, 58, 66–71. [Google Scholar] [CrossRef]
- Ibrahim, M.; Kabir, J.; Kwanashie, C.; Salawudeen, M.; Joshua, Z. Occurrence of mycotoxigenic fungi in poultry feeds at live-bird markets, Zaria, Nigeria. Sokoto J. Vet. Sci. 2017, 15, 53. [Google Scholar] [CrossRef][Green Version]
- Habib, M.; Abdu, P.; Kwanashie, C.; Kabir, J.; Negedu, A. Aflatoxin in slaughtered broiler livers from an upgraded and a local bird markets in two Local Government Areas of Kaduna State, Nigeria. Int. J. Food Res. 2015, 2, 12–15. [Google Scholar]
- Haruna, M.; Dangora, D.; Khan, A.; Batagarawa, U.; Ibrahim, H.; Adamu, S. Incidence of fungal flora and aflatoxin in some spices sold in central market, Funtua, Nigeria. MYU J. Microbiol. Res. 2017, 2, 47–53. [Google Scholar]
- Xu, H.; Annis, S.; Linz, J.; Trail, F. Infection and colonization of peanut pods by Aspergillus parasiticus and the expression of the aflatoxin biosynthetic gene, nor-1, in infection hyphae. Physiol. Mol. Plant Pathol. 2000, 56, 185–196. [Google Scholar] [CrossRef]
- Shukla, R.; Kumar, A.; Prasad, C.S.; Srivastava, B.; Dubey, N.K. Antimycotic and antiaflatoxigenic potency of Adenocalymma alliaceum Miers. on fungi causing biodeterioration of food commodities and raw herbal drugs. Int. Biodeterior. Biodegrad. 2008, 62, 348–351. [Google Scholar] [CrossRef]
- Bbosa, G.S.; Kitya, D.; Lubega, A.; Ogwal-Okeng, J.; Anokbonggo, W.W.; Kyegombe, D.B. Review of the biological and health effects of aflatoxins on body organs and body systems. Aflatoxins-Recent Adv. Future Prospect. 2013, 12, 239–265. [Google Scholar]
- Loi, M.; Paciolla, C.; Logrieco, A.F.; Mulè, G. Plant Bioactive Compounds in Pre- and Postharvest Management for Aflatoxins Reduction. Front. Microbiol. 2020, 11, 243. [Google Scholar] [CrossRef]
- Bruns, H.A. Controlling Aflatoxin and Fumonisin in Maize by Crop Management. J. Toxicol. Toxin Rev. 2003, 22, 153–173. [Google Scholar] [CrossRef]
- Abbas, H.; Wilkinson, J.; Zablotowicz, R.; Accinelli, C.; Abel, C.; Bruns, H.; Weaver, M. Ecology of Aspergillus flavus, regulation of aflatoxin production, and management strategies to reduce aflatoxin contamination of corn. Toxin Rev. 2009, 28, 142–153. [Google Scholar] [CrossRef]
- Sultana, T.; Javed, B.; Raja, N.I.; Mashwani, Z.-U. Silver nanoparticles elicited physiological, biochemical, and antioxidant modifications in rice plants to control Aspergillus flavus. Green Process. Synth. 2021, 10, 314–324. [Google Scholar] [CrossRef]
- Das, S.K.; Patra, J.K.; Thatoi, H. Antioxidative response to abiotic and biotic stresses in mangrove plants: A review. Int. Rev. Hydrobiol. 2015, 101, 3–19. [Google Scholar] [CrossRef]
- Smith, S.E.; Facelli, E.; Pope, S.; Smith, F.A. Plant performance in stressful environments: Interpreting new and established knowledge of the roles of arbuscular mycorrhizas. Plant Soil 2009, 326, 3–20. [Google Scholar] [CrossRef]
- Fouad, A.M.; Ruan, D.; El-Senousey, H.K.; Chen, W.; Jiang, S.; Zheng, C. Harmful Effects and Control Strategies of Aflatoxin B1 Produced by Aspergillus flavus and Aspergillus parasiticus Strains on Poultry: Review. Toxins 2019, 11, 176. [Google Scholar] [CrossRef] [PubMed]
- Leger, R.J.S.; Screen, S.E.; Shams-Pirzadeh, B. Lack of Host Specialization in Aspergillus flavus. Appl. Environ. Microbiol. 2000, 66, 320–324. [Google Scholar] [CrossRef] [PubMed]
- Guthman, J. Wilted: Pathogens, Chemicals, and the Fragile Future of the Strawberry Industry; University of California Press: Berkeley, CA, USA, 2019; Volume 6. [Google Scholar]
- Dubos, R.; Cooper, J.; Mechanic, D. So Human an Animal: How We Are Shaped by Surroundings and Events; Routledge: Oxfordshire, UK, 2017. [Google Scholar]
- Regis, N. Genetically Modified Crops and Food; Encyclopaedia Britannica: Scotland, UK, 2015. [Google Scholar]
- Nagel, R.N.; Dove, R. 21st Century Manufacturing Enterprise Strategy: An Industry-Led View; Diane Publishing: Collingdale, PA, USA, 1991. [Google Scholar]
- Wilson, C.L.; Wisniewski, M.E. Biological Control of Postharvest Diseases of Fruits and Vegetables: An Emerging Technology. Annu. Rev. Phytopathol. 1989, 27, 425–441. [Google Scholar] [CrossRef]
- Rausher, M.D. Co-evolution and plant resistance to natural enemies. Nature 2001, 411, 857–864. [Google Scholar] [CrossRef]
- Khalil, A.; Abdelaziz, A.; Khaleil, M.; Hashem, A. Fungal endophytes from leaves of Avicennia marina growing in semi-arid environment as a promising source for bioactive compounds. Lett. Appl. Microbiol. 2020, 72, 263–274. [Google Scholar] [CrossRef]
- Sharaf, M.H.; Abdelaziz, A.M.; Kalaba, M.H.; Radwan, A.A.; Hashem, A.H. Antimicrobial, Antioxidant, Cytotoxic Activities and Phytochemical Analysis of Fungal Endophytes Isolated from Ocimum Basilicum. Appl. Biochem. Biotechnol. 2021, 194, 1271–1289. [Google Scholar] [CrossRef]
- Badawy, A.; Alotaibi, M.; Abdelaziz, A.; Osman, M.; Khalil, A.; Saleh, A.; Mohammed, A.; Hashem, A. Enhancement of Seawater Stress Tolerance in Barley by the Endophytic Fungus Aspergillus Ochraceus. Metabolites 2021, 11, 428. [Google Scholar] [CrossRef]
- Aldinary, A.M.; Abdelaziz, A.M.; Farrag, A.A.; Attia, M.S. Biocontrol of tomato Fusarium wilt disease by a new Moringa endophytic Aspergillus isolates. Mater. Today Proc. 2021, in press. [Google Scholar] [CrossRef]
- Houshyar-Fard, M.; Rouhani, H.; Falahati-Rastegar, M.; Mahdikhani-Moghaddam, E.; Malekzadeh-Shafaroudi, S.; Probst, C. Studies on Aspergillus flavus Link. isolated from maize in Iran. J. Plant Prot. Res. 2014, 54. [Google Scholar] [CrossRef]
- Hashem, A.H.; Abu-Elreesh, G.; El-Sheikh, H.H.; Suleiman, W.B. Isolation, identification, and statistical optimization of a psychrotolerant Mucor racemosus for sustainable lipid production. Biomass-Convers. Biorefinery 2022, 1–12. [Google Scholar] [CrossRef]
- Hashem, A.H.; Hasanin, M.S.; Khalil, A.M.A.; Suleiman, W.B. Eco-Green Conversion of Watermelon Peels to Single Cell Oils Using a Unique Oleaginous Fungus: Lichtheimia corymbifera AH13. Waste Biomass-Valorization 2019, 11, 5721–5732. [Google Scholar] [CrossRef]
- Hashem, A.H.; Suleiman, W.B.; Abu-Elreesh, G.; Shehabeldine, A.M.; Khalil, A.M.A. Sustainable lipid production from oleaginous fungus Syncephalastrum racemosum using synthetic and watermelon peel waste media. Bioresour. Technol. Rep. 2020, 12, 100569. [Google Scholar] [CrossRef]
- Hashem, A.H.; Suleiman, W.B.; Abu-Elrish, G.M.; El-Sheikh, H.H. Consolidated Bioprocessing of Sugarcane Bagasse to Microbial Oil by Newly Isolated Oleaginous Fungus: Mortierella wolfii. Arab. J. Sci. Eng. 2020, 46, 199–211. [Google Scholar] [CrossRef]
- Hasanin, M.; Hashem, A.H.; Lashin, I.; Hassan, S.A.M. In vitro improvement and rooting of banana plantlets using antifungal nanocomposite based on myco-synthesized copper oxide nanoparticles and starch. Biomass-Convers. Biorefinery 2021, 1–11. [Google Scholar] [CrossRef]
- Singh, L.; Sati, S.C. Antagonistic Activity of Isolated Root Endophytic Freshwater Fungus Anguillospora Longissima against Pathogenic Fungi. Natl. Acad. Sci. Lett. 2019, 43, 201–205. [Google Scholar] [CrossRef]
- Khan, R.; Ghazali, F.M.; Mahyudin, N.A.; Samsudin, N.I.P. Chromatographic analysis of aflatoxigenic Aspergillus flavus isolated from Malaysian sweet corn. Separations 2021, 8, 98. [Google Scholar] [CrossRef]
- Scott, P.M. Mycotoxin methodology. Food Addit. Contam. 1995, 12, 395–403. [Google Scholar] [CrossRef]
- El-Taher, E.M.; TM, A.E.-G.; Ashour, M.S. Biosecurity for reducing ochratoxin A productivity and their impact on germination and ultrastructures of germinated wheat grains. J. Microbiol. Biotechnol. Food Sci. 2021, 2021, 135–151. [Google Scholar]
- Tédihou, E.; Olatinwo, R.; Hell, K.; Hau, B.; Hoogenboom, G. Effects of variety, cropping system and soil inoculation with Aspergillus flavus on aflatoxin levels during storage of maize. Trop. Plant Pathol. 2012, 37, 25–36. [Google Scholar] [CrossRef][Green Version]
- Attia, M.S.; El-Sayyad, G.S.; Abd Elkodous, M.; El-Batal, A.I. The effective antagonistic potential of plant growth-promoting rhizobacteria against Alternaria solani-causing early blight disease in tomato plant. Sci. Hortic. 2020, 266, 109289. [Google Scholar] [CrossRef]
- Lichtenthaler, H.K.; Buschmann, C. Chlorophylls and Carotenoids: Measurement and Characterization by UV-VIS Spectroscopy. Curr. Protoc. Food Anal. Chem. 2001, 1, F4.3.1–F4.3.8. [Google Scholar] [CrossRef]
- Hu, Z.; Richter, H.; Sparovek, G.; Schnug, E. Physiological and Biochemical Effects of Rare Earth Elements on Plants and Their Agricultural Significance: A Review. J. Plant Nutr. 2004, 27, 183–220. [Google Scholar] [CrossRef]
- Mukherjee, S.P.; Choudhuri, M.A. Implications of water stress-induced changes in the levels of endogenous ascorbic acid and hydrogen peroxide in Vigna seedlings. Physiol. Plant. 1983, 58, 166–170. [Google Scholar] [CrossRef]
- Dai, G.; Andary, C.; Cosson-Mondolot, L.; Boubals, D. Polyphenols and resistance of grapevines to downy mildew. In International Symposium on Natural Phenols in Plant Resistance; Acta Horticulturae 381; ISHS: Wageningen, The Netherlands, 1993; pp. 763–766. [Google Scholar]
- Bates, L.S.; Waldren, R.P.; Teare, I.D. Rapid determination of free proline for water-stress studies. Plant Soil 1973, 39, 205–207. [Google Scholar] [CrossRef]
- Bergmeyer, H. Determination with glucose oxidase and peroxidase. In Methods of Enzymatic Analysis; Verlag Chemie: Weinheim, Germany, 1974; pp. 1205–1215. [Google Scholar]
- Kong, F.; Hu, W.; Chao, S.; Sang, W.; Wang, L. Physiological responses of the lichen Xanthoparmelia mexicana to oxidative stress of SO2. Environ. Exp. Bot. 1999, 42, 201–209. [Google Scholar] [CrossRef]
- Chen, Y.; Cao, X.; Lu, Y.; Wang, X. Effects of rare earth metal ions and their EDTA complexes on antioxidant enzymes of fish liver. Bull. Environ. Contam. Toxicol. 2000, 65, 357–365. [Google Scholar] [CrossRef] [PubMed]
- Abdallah, M.F.; De Boevre, M.; Landschoot, S.; De Saeger, S.; Haesaert, G.; Audenaert, K. Fungal endophytes control Fusarium graminearum and reduce trichothecenes and zearalenone in maize. Toxins 2018, 10, 493. [Google Scholar] [CrossRef] [PubMed]
- Lin, N.-S.; Langenberg, W. Immunohistochemical localization of barley stripe mosaic virions in infected wheat cells. J. Ultrastruct. Res. 1983, 84, 16–23. [Google Scholar] [CrossRef]
- Lillehoj, E.B.; Kwolek, W.F.; Vandegraft, E.E.; Zuber, M.S.; Calvert, O.H.; Widstrom, N.; Futrell, M.C.; Bockholt, A.J. Aflatoxin Production in Aspergillus flavus Inoculated Ears of Corn Grown at Diverse Locations. Crop Sci. 1975, 15, 267–270. [Google Scholar] [CrossRef]
- Bankole, S.; Adebanjo, A. Mycotoxins in food in West Africa: Current situation and possibilities of controlling it. Afr. J. Biotechnol. 2003, 2, 254–263. [Google Scholar]
- Hashem, A.H.; Shehabeldine, A.M.; Abdelaziz, A.M.; Amin, B.H.; Sharaf, M.H. Antifungal Activity of Endophytic Aspergillus terreus Extract Against Some Fungi Causing Mucormycosis: Ultrastructural Study. Appl. Biochem. Biotechnol. 2022, 1–15. [Google Scholar] [CrossRef] [PubMed]
- Kaur, N.; Arora, D.S.; Kaur, S.; Kumar, A.; Kaur, S. Antiproliferative and Oxidative Damage Protection Activities of Endophytic Fungi Aspergillus fumigatus and Chaetomium globosum from Moringa oleifera Lam. Appl. Biochem. Biotechnol. 2021, 193, 3570–3585. [Google Scholar] [CrossRef] [PubMed]
- Kaur, N.; Arora, D.S.; Kalia, N.; Kaur, M. Antibiofilm, antiproliferative, antioxidant and antimutagenic activities of an endophytic fungus Aspergillus fumigatus from Moringa oleifera. Mol. Biol. Rep. 2020, 47, 2901–2911. [Google Scholar] [CrossRef] [PubMed]
- Howell, C.R. Mechanisms Employed by Trichoderma Species in the Biological Control of Plant Diseases: The History and Evolution of Current Concepts. Plant Dis. 2003, 87, 4–10. [Google Scholar] [CrossRef] [PubMed]
- Goswami, R.S.; Kistler, H.C. Heading for disaster: Fusarium graminearum on cereal crops. Mol. Plant Pathol. 2004, 5, 515–525. [Google Scholar] [CrossRef]
- IARC Working Group on the Evaluation of Carcinogenic Risks to Humans and International Agency for Research on Cancer. Some Traditional Herbal Medicines, Some Mycotoxins, Naphthalene and Styrene; World Health Organization: Geneva, Switzerland, 2002; Volume 82. [Google Scholar]
- Savić, Z.; Dudaš, T.; Loc, M.; Grahovac, M.; Budakov, D.; Jajić, I.; Krstović, S.; Barošević, T.; Krska, R.; Sulyok, M. Biological control of aflatoxin in maize grown in Serbia. Toxins 2020, 12, 162. [Google Scholar] [CrossRef]
- Richard, E.; Heutte, N.; Bouchart, V.; Garon, D. Evaluation of fungal contamination and mycotoxin production in maize silage. Anim. Feed Sci. Technol. 2009, 148, 309–320. [Google Scholar] [CrossRef]
- Bandyopadhyay, R.; Ortega-Beltran, A.; Akande, A.; Mutegi, C.; Atehnkeng, J.; Kaptoge, L.; Senghor, A.; Adhikari, B.; Cotty, P. Biological control of aflatoxins in Africa: Current status and potential challenges in the face of climate change. World Mycotoxin J. 2016, 9, 771–789. [Google Scholar] [CrossRef]
- Abbas, H.K.; Weaver, M.A.; Horn, B.W.; Carbone, I.; Monacell, J.T.; Shier, W.T. Selection of Aspergillus flavus isolates for biological control of aflatoxins in corn. Toxin Rev. 2011, 30, 59–70. [Google Scholar] [CrossRef]
- Wu, Q.; Jezkova, A.; Yuan, Z.; Pavlikova, L.; Dohnal, V.; Kuca, K. Biological degradation of aflatoxins. Drug Metab. Rev. 2009, 41, 1–7. [Google Scholar] [CrossRef] [PubMed]
- Damann, J. Atoxigenic Aspergillus flavus biological control of aflatoxin contamination: What is the mechanism? World Mycotoxin J. 2015, 8, 235–244. [Google Scholar] [CrossRef]
- Reverberi, M.; Fabbri, A.A.; Zjalic, S.; Ricelli, A.; Punelli, F.; Fanelli, C. Antioxidant enzymes stimulation in Aspergillus parasiticus by Lentinula edodes inhibits aflatoxin production. Appl. Microbiol. Biotechnol. 2005, 69, 207–215. [Google Scholar] [CrossRef] [PubMed]
- Divakara, S.; Aiyaz, M.; Nayaka, S.; Niranjana, S. Effect of toxigenic Aspergillus flavus and aflatoxins on seed quality parameters of Sorghum bicolor (L.). Moench. Microb. Biosyst. 2017, 2, 1–8. [Google Scholar]
- Ismaiel, A.A.; Papenbrock, J. Mycotoxins: Producing Fungi and Mechanisms of Phytotoxicity. Agriculture 2015, 5, 492–537. [Google Scholar] [CrossRef]
- El-Naghy, M.A.; Fadl-Allah, E.M.; Samhan, M. Effect of aflatoxin G1 on germination, growth and metabolic activities of some crop plants. Cytobios 1999, 97, 87–93. [Google Scholar]
- Bhat, M.Y.; Fazal, M. Short Communication (Biology: Fungi) Effect of Aspergillus flavus Metabolites on Wheat Seed Germination and Seedlings Growth. Growth 2011, 29, 139–140. [Google Scholar]
- Kagot, V.; Okoth, S.; De Boevre, M.; De Saeger, S. Biocontrol of Aspergillus and Fusarium Mycotoxins in Africa: Benefits and Limitations. Toxins 2019, 11, 109. [Google Scholar] [CrossRef]
- Nihorimbere, V.; Ongena, M.; Smargiassi, M.; Thonart, P. Beneficial effect of the rhizosphere microbial community for plant growth and health. Biotechnol. Agron. Société Environ. 2011, 15, 327–337. [Google Scholar]
- Bilal, L.; Asaf, S.; Hamayun, M.; Gul, H.; Iqbal, A.; Ullah, I.; Lee, I.-J.; Hussain, A. Plant growth promoting endophytic fungi Asprgillus fumigatus TS1 and Fusarium proliferatum BRL1 produce gibberellins and regulates plant endogenous hormones. Symbiosis 2018, 76, 117–127. [Google Scholar] [CrossRef]
- Kumari, P.; Kumar, S.; Patra, A.; Singh, B.; Pandey, V.; Mehta, S. Plant-Microbe Symbiosis led synthesis of Bioactive Compounds. In Antioxidants in Plant-Microbe Interaction; Springer: Berlin/Heidelberg, Germany, 2021; pp. 21–40. [Google Scholar] [CrossRef]
- Meena, H.; Hnamte, S.; Siddhardha, B. Secondary Metabolites from Endophytic Fungi: Chemical Diversity and Application. In Advances in Endophytic Fungal Research; Springer: Berlin/Heidelberg, Germany, 2019; pp. 145–169. [Google Scholar] [CrossRef]
- Kretschmer, M.; Damoo, D.; Djamei, A.; Kronstad, J. Chloroplasts and Plant Immunity: Where Are the Fungal Effectors? Pathogens 2020, 9, 19. [Google Scholar] [CrossRef] [PubMed]
- Fernandes, J.C.; Henriques, F.S. Biochemical, physiological, and structural effects of excess copper in plants. Bot. Rev. 1991, 57, 246–273. [Google Scholar] [CrossRef]
- Georgieva, P. Determination of Gibberella Ear Rot Resistance in New Maize Hybrids. Master’s Thesis, University for Natural Resources and Life Sciences, Vienna, Austria, 2015. [Google Scholar]
- Zhang, F.; Yuan, J.; Yang, X.; Cui, Y.; Chen, L.; Ran, W.; Shen, Q. Putative Trichoderma harzianum mutant promotes cucumber growth by enhanced production of indole acetic acid and plant colonization. Plant Soil 2012, 368, 433–444. [Google Scholar] [CrossRef]
- Qin, W.; Liu, C.; Jiang, W.; Xue, Y.; Wang, G.; Liu, S. A coumarin analogue NFA from endophytic Aspergillus fumigatus improves drought resistance in rice as an antioxidant. BMC Microbiol. 2019, 19, 50. [Google Scholar] [CrossRef]
- Ali, S.; Charles, T.C.; Glick, B.R. Endophytic Phytohormones and Their Role in Plant Growth Promotion. In Functional Importance of the Plant Microbiome; Springer: Berlin/Heidelberg, Germany, 2017; pp. 89–105. [Google Scholar] [CrossRef]
- Caretto, S.; Linsalata, V.; Colella, G.; Mita, G.; Lattanzio, V. Carbon Fluxes between Primary Metabolism and Phenolic Pathway in Plant Tissues under Stress. Int. J. Mol. Sci. 2015, 16, 26378–26394. [Google Scholar] [CrossRef]
- Dar, S.A.; Rather, B.; Wani, A.; Ganie, M. Resistance against insect pests by plant phenolics and their derivative compounds. Chem. Sci. Rev. Lett. 2017, 6, 1073–1081. [Google Scholar]
- Jan, F.G.; Hamayun, M.; Hussain, A.; Jan, G.; Iqbal, A.; Khan, A.; Lee, I.-J. An endophytic isolate of the fungus Yarrowia lipolytica produces metabolites that ameliorate the negative impact of salt stress on the physiology of maize. BMC Microbiol. 2019, 19, 3. [Google Scholar] [CrossRef]
- Hashem, A.H.; Khalil, A.M.A.; Reyad, A.M.; Salem, S.S. Biomedical Applications of Mycosynthesized Selenium Nanoparticles Using Penicillium expansum ATTC 36200. Biol. Trace Element Res. 2021, 199, 3998–4008. [Google Scholar] [CrossRef]
- Mandal, S.M.; Chakraborty, D.; Dey, S. Phenolic acids act as signaling molecules in plant-microbe symbioses. Plant Signal. Behav. 2010, 5, 359–368. [Google Scholar] [CrossRef]
- Ashraf, M.A.; Iqbal, M.; Rasheed, R.; Hussain, I.; Riaz, M.; Arif, M.S. Environmental stress and secondary metabolites in plants: An overview. Plant Metab. Regul. Under Environ. Stress 2018, 153–167. [Google Scholar] [CrossRef]
- Ben Rejeb, K.; Abdelly, C.; Savouré, A. How reactive oxygen species and proline face stress together. Plant Physiol. Biochem. 2014, 80, 278–284. [Google Scholar] [CrossRef] [PubMed]
- Soshinkova, T.N.; Radyukina, N.L.; Korolkova, D.V.; Nosov, A.V. Proline and functioning of the antioxidant system in Thellungiella salsuginea plants and cultured cells subjected to oxidative stress. Russ. J. Plant Physiol. 2012, 60, 41–54. [Google Scholar] [CrossRef]
- Michalak, A. Phenolic compounds and their antioxidant activity in plants growing under heavy metal stress. Pol. J. Environ. Stud. 2006, 15, 523–530. [Google Scholar]
- Duc, N.; Mayer, Z.; Pék, Z.; Helyes, L.; Posta, K. Combined inoculation of arbuscular mycorrhizal fungi, Pseudomonas fluorescens and Trichoderma spp. for enhancing defense enzymes and yield of three pepper cultivars. Appl. Ecol. Environ. Res. 2017, 15, 1815–1829. [Google Scholar] [CrossRef]
- Ismaiel, A.; Tharwat, N. Antifungal activity of silver ion on ultrastructure and production of aflatoxin B1 and patulin by two mycotoxigenic strains, Aspergillus flavus OC1 and Penicillium vulpinum CM1. J. Mycol. Médicale 2014, 24, 193–204. [Google Scholar] [CrossRef]
- Chen, J. Microbial Enzymes Associated with Fresh-cut Produce. In Fresh-Cut Fruits and Vegetables: Science, Technology and Market; CRC Press: Boca Raton, FL, USA, 2002; pp. 249–266. [Google Scholar] [CrossRef]
- Narayanasamy, P. Microbial Plant Pathogens and Crop Disease Management; CRC Press: Boca Raton, FL, USA, 2002. [Google Scholar]
- McLean, M.; Berjak, P.; Watt, M.P.; Dutton, M.F. The effects of aflatoxin B1 on immature germinating maize (Zea mays) embryos. Mycopathologia 1992, 119, 181–190. [Google Scholar] [CrossRef]
- Li, Q.; Zhu, X.; Xie, Y.; Zhong, Y. o-Vanillin, a promising antifungal agent, inhibits Aspergillus flavus by disrupting the integrity of cell walls and cell membranes. Appl. Microbiol. Biotechnol. 2021, 105, 5147–5158. [Google Scholar] [CrossRef] [PubMed]
- Cazacu, G.; Capraru, M.; Popa, V.I. Advances Concerning Lignin Utilization in New Materials. In Advances in Natural Polymers; Springer: Berlin/Heidelberg, Germany, 2012; pp. 255–312. [Google Scholar] [CrossRef]

| Aflatoxin Type | Aflatoxin (ng/mL) | Inhibition % | |
|---|---|---|---|
| Control | Treated | ||
| AFG1 | 6.88 | 1.40 | 79.6 |
| AFG2 | ND | ND | ND |
| AFB1 | 3647.15 | 332.50 | 90.90 |
| AFB2 | 99.39 | 6.80 | 93.10 |
| Aflatoxin Type | Aflatoxin (ng/g) | Inhibition % | ||
|---|---|---|---|---|
| Control Healthy | Control Infected | Treated with A. fumigatus | ||
| AFG1 | ND | ND | ND | ND |
| AFG2 | ND | 1.11 | ND | 100.00 |
| AFB1 | 4.60 | 794.09 | 462.57 | 41.74 |
| AFB2 | ND | 4.37 | 1.63 | 62.70 |
| Treatment | Germination % | Shoot Length (cm) | Root Length (cm) |
|---|---|---|---|
| Healthy control | 87 ± 1.00 a | 13.66 ± 1.00 a | 5.66 ± 0.57 a |
| Infected control | 40.66 ± 1.52 c | 6.00 ± 1.00 b | 1.83 ± 0.28 b |
| Infected treated with A. fumigatus | 76.66 ± 0.57 b | 13.0 ± 1.53 a | 6.33 ± 0.58 a |
| LSD at 0.05 | 2.2 | 2.4 | 0.99 |
Publisher’s Note: MDPI stays neutral with regard to jurisdictional claims in published maps and institutional affiliations. |
© 2022 by the authors. Licensee MDPI, Basel, Switzerland. This article is an open access article distributed under the terms and conditions of the Creative Commons Attribution (CC BY) license (https://creativecommons.org/licenses/by/4.0/).
Share and Cite
Abdelaziz, A.M.; El-Wakil, D.A.; Attia, M.S.; Ali, O.M.; AbdElgawad, H.; Hashem, A.H. Inhibition of Aspergillus flavus Growth and Aflatoxin Production in Zea mays L. Using Endophytic Aspergillus fumigatus. J. Fungi 2022, 8, 482. https://doi.org/10.3390/jof8050482
Abdelaziz AM, El-Wakil DA, Attia MS, Ali OM, AbdElgawad H, Hashem AH. Inhibition of Aspergillus flavus Growth and Aflatoxin Production in Zea mays L. Using Endophytic Aspergillus fumigatus. Journal of Fungi. 2022; 8(5):482. https://doi.org/10.3390/jof8050482
Chicago/Turabian StyleAbdelaziz, Amer M., Deiaa A. El-Wakil, Mohamed S. Attia, Omar M. Ali, Hamada AbdElgawad, and Amr H. Hashem. 2022. "Inhibition of Aspergillus flavus Growth and Aflatoxin Production in Zea mays L. Using Endophytic Aspergillus fumigatus" Journal of Fungi 8, no. 5: 482. https://doi.org/10.3390/jof8050482
APA StyleAbdelaziz, A. M., El-Wakil, D. A., Attia, M. S., Ali, O. M., AbdElgawad, H., & Hashem, A. H. (2022). Inhibition of Aspergillus flavus Growth and Aflatoxin Production in Zea mays L. Using Endophytic Aspergillus fumigatus. Journal of Fungi, 8(5), 482. https://doi.org/10.3390/jof8050482

